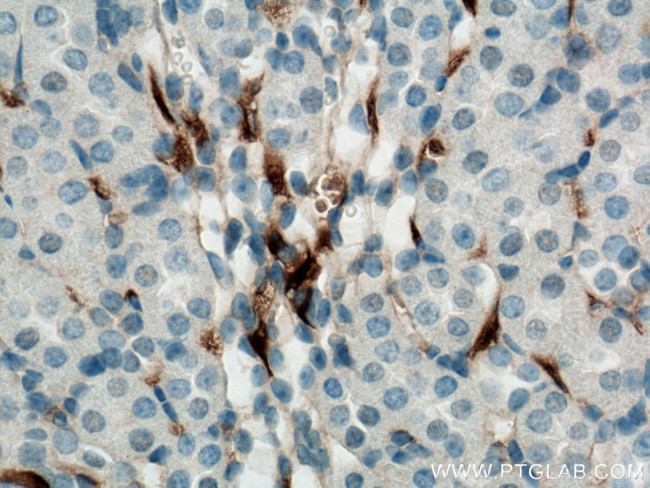
GPR126 Antibody in Immunohistochemistry (Paraffin) (IHC (P))

Search
Proteintech
GPR126 Polyclonal Antibody
{{$productOrderCtrl.translations['antibody.pdp.commerceCard.promotion.promotions']}}
{{$productOrderCtrl.translations['antibody.pdp.commerceCard.promotion.viewpromo']}}
{{$productOrderCtrl.translations['antibody.pdp.commerceCard.promotion.promocode']}}: {{promo.promoCode}} {{promo.promoTitle}} {{promo.promoDescription}}. {{$productOrderCtrl.translations['antibody.pdp.commerceCard.promotion.learnmore']}}
产品信息
17774-1-AP
种属反应
宿主/亚型
分类
类型
抗原
偶联物
形式
浓度
规格
纯化类型
保存液
内含物
保存条件
运输条件
产品详细信息
Aliquoting is unnecessary for -20°C storage.
靶标信息
GPR126 encodes a product that is upregulated in human umbilical vein endothelial cells, encodes a G protein-coupled receptor. Variations in this gene can affect a persoNULLs stature. Multiple transcript variants encoding different proteins have been found for this gene.
仅用于科研。不用于诊断过程。未经明确授权不得转售。
生物信息学
蛋白别名: Adhesion G-protein coupled receptor G6; Developmentally regulated G-protein-coupled receptor; G protein-coupled receptor 126; G-protein coupled receptor 126; HBV PreS1-transactivated protein 2; probable G-protein coupled receptor 126; PS1TP2; unnamed protein product; Vascular inducible G protein-coupled receptor; vascular-inducible G protein-coupled receptor
基因别名: 1190004A11Rik; ADGRG6; AI449247; APG1; AW045736; DREG; Gm222; GPR126; LCCS9; PR126; PS1TP2; VIGR
UniProt ID: (Human) Q86SQ4, (Mouse) Q6F3F9
Entrez Gene ID: (Human) 57211, (Mouse) 215798, (Rat) 308376